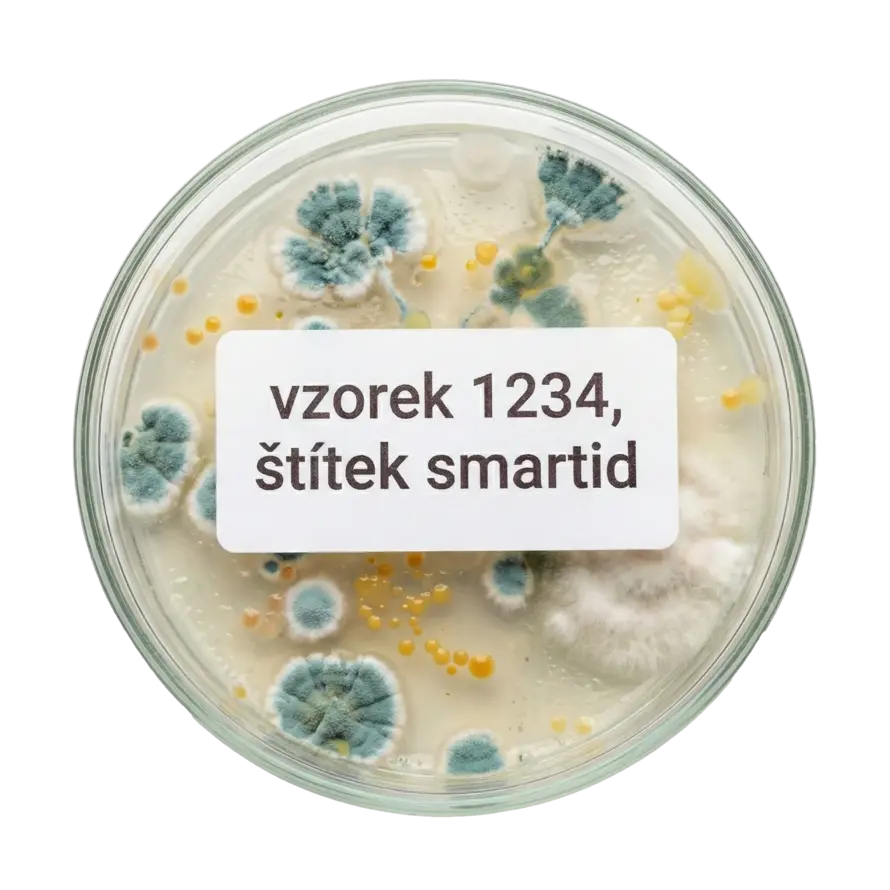
Každý vzorek má svou identitu: Spouštíme specializovaný portál SmartID Lab

Každý vzorek má svou identitu: Spouštíme specializovaný portál SmartID Lab
Přidáno 18. 12. 2025 10:02:25
SmartID Lab – specializovaný portál pro profesionální laboratorní značení. Objevte řešení, která odolají tekutému dusíku, autoklávu i agresivní chemii, a zajistěte svým vzorkům stoprocentní identitu.
Každý vzorek má svou identitu: Spouštíme specializovaný portál SmartID Lab
Věda a výzkum vyžadují stoprocentní přesnost. Zatímco na našem hlavním e-shopu najdete široké portfolio identifikačních prvků, uvědomujeme si, že laboratorní prostředí má svá specifická a velmi přísná pravidla. Proto jsme spustili nový portál lab.smartid.cz, který se věnuje výhradně komplexnímu řešení laboratorního značení.
Proč vznikl SmartID Lab?
Laboratorní vzorky jsou často nenahraditelné. Ztráta čitelnosti štítku vlivem mrazu nebo chemikálií může znamenat znehodnocení měsíců práce. Na lab.smartid.cz najdete řešení, která využívají špičkové materiály od americké společnosti Brady Corporation, navržené pro ty nejnáročnější podmínky.
Co na novém webu najdete?
Portál jsme postavili tak, abyste snadno našli řešení přesně pro váš typ aplikace.
1. Kompletní řešení podle typu značení
Už nemusíte hádat, který štítek je ten pravý. Připravili jsme přehledné sekce pro všechny laboratorní aplikace:
- Zkumavky – Odolnost pro centrifugy a tekutý dusík.
- Petriho misky – Průhledné i barevné značení bez omezení výhledu.
- Stébla a tyčinky – Samolaminovací štítky pro extrémně úzké průměry.
- Mikrodestičky – Stabilita při termocyklování a mrazu.
- Podložní sklíčka – Odolnost vůči barvivům a xylenu.
- Tkáňové kazety – Značení, které přežije parafínovou lázeň.
- Laboratorní sklo – Štítky rozpustné ve vodě i permanentní řešení.
- Obecné značení – Identifikace krabic, regálů a vybavení v laboratoři.
2. Extrémní odolnost v hlavní roli
V laboratoři se materiály setkávají s extrémy. Na webu detailně rozebíráme, jak naše štítky zvládají:
- Tekutý dusík (-196 °C): Adheziva, která nekrystalizují a drží i v kryogenních podmínkách.
- Autokláv a sterilizace (130 °C): Odolnost vůči tlaku a vysoké teplotě bez deformace.
- Chemická odolnost: Ochrana proti agresivním činidlům, jako je xylen, DMSO nebo ethanol.
3. Výběr laboratorních tiskáren
Správný štítek vyžaduje správný tisk. Na webu najdete srovnání tiskáren Brady:
- Řada M2 (M210/M211) – Kompaktní řešení pro standardní aplikace.
- Řada M5 (M510/M511) – Pro speciální materiály a maximální šíři tisku.
- Stolní tiskárna BBP12 – Pro vysokokapacitní tisk stovek štítků denně.
Řešení na míru zdarma
Víme, že každá laboratoř je unikátní. Pokud si nejste jisti výběrem, na novém portálu můžete přímo kontaktovat našeho specialistu. Zdarma pro vás navrhneme funkční systém značení.
Prozkoumejte všechny možnosti na: lab.smartid.cz
Pro nákup standardního vybavení můžete i nadále využívat náš hlavní smartid-eshop.cz.
